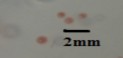
Khuẩn lạc tròn bóng rìa trong có nhân đỏ nhạt đường kính 1 mm Phenol Mẫu 9
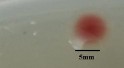
Khuẩn lạc hồng nhạt có nhân màu đỏ nhớt có rìa đường kính 5 mm 15

Bảng 3.1. Kết quả phân lập các khuẩn lạc VKTQH từ nguồn mẫu nước bị ô nhiễm dầu mỏ ở các vùng biển Việt Nam
Ký hiệu khuẩn lạc | Hình ảnh khuẩn lạc | Hình thái, màu sắc, kích thước khuẩn lạc | Nguồn cơ chất | Nguồn phân lập | |
1. | DQ41 (DD4) |
| Khuẩn lạc tròn, lồi, bóng, có rìa trong, không nhân, màu đỏ đậm, đường kính 1 - 1,5mm | Toluene | Mẫu nước nhiễm dầu tại vùng biển Quãng Ngãi |
2. | DQ42 |
| Khuẩn lạc tròn, lồi, rìa trong, loang, màu tím tía, đường kính 1mm | Toluene | Mẫu nước nhiễm dầu tại vùng biển Quãng Ngãi |
3. | DQ51 |
| Khuẩn lạc tròn, trơn, bóng, có rìa phẳng, màu đỏ tía, đường kính 0,5 mm | Toluene | Mẫu nước nhiễm dầu tại vùng biển Quãng Ngãi |
4. | DQ52 |
| Khuẩn lạc tròn, trơn, bóng, có rìa trong, màu đỏ tía, đường kính < 0.5mm | Toluene | Mẫu nước nhiễm dầu tại vùng biển Quãng Ngãi |
5. | DQ81 |
| Khuẩn lạc tròn, lồi, nhẵn bóng, rìa trong và phẳng, có nhân, màu đỏ đậm, đường kính 2 - 2,5 mm | Napthalene | Mẫu nước nhiễm dầu tại vùng biển Quãng Ngãi |
6. | DQ82 |
| Khuẩn lạc tròn, lồi, bóng, có nhân, có chân, màu đỏ gạch, đường kính 1,5 mm | Napthalene | Mẫu nước nhiễm dầu tại vùng biển Quãng Ngãi |
7. | FO1 |
| Khuẩn lạc tròn, lồi, trơn, bóng, rìa loang, đỏ tía, đường kính 1 mm | Dầu diesel | Mẫu nước nhiễm dầu tại vùng biển Vũng Tàu |
8. | FO2 |
| Khuẩn lạc tròn, trơn, rìa loang, đỏ nhạt, đường kính < 0,5 mm | Dầu diesel | Mẫu nước nhiễm dầu tại vùng biển Vũng Tàu |
Có thể bạn quan tâm!
-
Ứng Dụng Vi Khuẩn Tía Quang Hợp Để Phân Hủy Hydrocarbon Dầu Mỏ -
Sơ Đồ Các Bước Thí Nghiệm Thực Hiện Trong Luận Án -
Phương Pháp Nghiên Cứu Hệ Sắc Tố Của Vi Khuẩn Tía Quang Hợp -
Khả Năng Sinh Trưởng Của 10 Chủng Vktqh Ở Các Nồng Độ Naphthalene Khác Nhau Sau 7 Ngày Nuôi Cấy -
Ảnh Hưởng Của Một Số Điều Kiện Môi Trường Đến Sự Hình Thành Màng Sinh Học Của 3 Chủng Vktqh -
Thí Nghiệm Đánh Giá Sự Đối Kháng Lẫn Nhau Của Các Chủng Vktqh Lựa Chọn. (1)- Dq41; (2)- Dd4; (3),- Fo2
Xem toàn bộ 144 trang tài liệu này.
Ký hiệu khuẩn lạc | Hình ảnh khuẩn lạc | Hình thái, màu sắc, kích thước khuẩn lạc | Nguồn cơ chất | Nguồn phân lập | |
9. | DD3 |
| Khuẩn lạc tròn, bóng, rìa trong, có nhân, đỏ nhạt, đường kính 1 mm | Phenol | Mẫu bùn nhiễm dầu tại vùng biển Quãng Ngãi |
10. | DD4 |
| Khuẩn lạc tròn, nhỏ li ti, màu đỏ nhạt | Phenol | Mẫu bùn nhiễm dầu tại vùng biển Quãng Ngãi |
11. | PY2 |
| Khuẩn lạc có nhân, lồi, tròn, bề mặt bóng, màu nâu vàng, đường kính 0.8-1.2 mm. | Pyrene | Cảng cầu đá Nha Trang - Khánh Hòa |
12. | PY6 |
| Khuẩn lạc có nhân màu nâu đậm hơn, mép loang, màu nâu vàng, đường kính 1.5 mm. | Pyrene | Cảng cầu đá Nha Trang - Khánh Hòa |
13. | PY9 |
| Khuẩn lạc màu hồng nhạt, có nhân, rìa trong, đường kính 1-2 mm. | Pyrene | Cảng cầu đá Nha Trang - Khánh Hòa |
14. | LC1 |
| Khuẩn lạc tròn, lồi, trơn, bóng, màu đỏ nhạt, rìa trong, đường kính 2-2.5 mm. | Anthracene | Làng chài Nha Trang – Khánh Hòa |
15. | LC5 |
| Khuẩn lạc hồng nhạt, có nhân màu đỏ, nhớt, có rìa, đường kính 5 mm. | Anthracene | Làng chài Nha Trang – Khánh Hòa |
3.1.2. Tuyển chọn các chủng VKTQH có khả năng tạo màng sinh học và phân hủy hydrocarbon dầu mỏ
3.1.2.1. Đánh giá khả năng sinh trưởng và tạo màng sinh học của các chủng vi khuẩn tía quang hợp
Các chủng VKTQH sau khi được phân lập và làm sạch cùng 17 chủng VKTQH trong bộ sưu tập được tuyển chọn theo phương pháp 2.2.1.4 chương 2 được nuôi trong môi trường DSMZ 27 để đánh giá khả năng sinh trưởng và tạo màng sinh học. Bảng 3.2 trình bày kết quả xác định khả năng sinh trưởng của 32 chủng VKTQH phân lập được sau 7 ngày nuôi cấy:
Bảng 3.2. Khả năng sinh trưởng của các chủng VKTQH
Ký hiệu chủng | ∆OD800 | |
1. | FO2 | 1.291±0.01 |
2. | DQ52 | 1.283±0.012 |
3. | DQ41 (DD4) | 1.257±0.01 |
4. | DQ42 | 1.25±0.02 |
5. | DD3 | 1.228±0.03 |
6. | DD4 | 1.222±0.01 |
7. | DQ51 | 1.21±0.02 |
8. | DQ82 | 1.19±0.012 |
9. | FO1 | 1.163±0.01 |
10. | DQ81 | 1.162±0.018 |
11. | DG211 | 0.99±0.06 |
12. | QP21 | 0.99±0.02 |
13. | DG217 | 0.98±0.01 |
14. | DG114 | 0.97±0.038 |
15. | DG12 | 0.97±0.024 |
Ký hiệu chủng | ∆OD800 | |
16. | PY6 | 0.97±0.023 |
17. | LACM2I2 | 0.96±0.01 |
18. | NMS412 | 0.95±0.023 |
19. | A3II3 | 0.94±0.026 |
20. | PY2 | 0.93±0.03 |
21. | DG218 | 0.91±0.05 |
22. | LC1 | 0.90±0.01 |
23. | MI1 | 0.87±0.04 |
24. | DG213 | 0.84±0.018 |
25. | NMS25 | 0.82±0.02 |
26. | VH | 0.82±0.01 |
27. | LC5 | 0.78±0.03 |
28. | DG214 | 0.77±0.011 |
29. | NMS411 | 0.76±0.01 |
30. | PY9 | 0.74±0.01 |
31. | HQP304 | 0.73±0.03 |
32. | LACM1 | 0.71±0.01 |
Kết quả cho thấy, tất cả 32 chủng VKTQH đều sinh trưởng tốt trên môi trường DSMZ 27, trong đó có 10 chủng có kí hiệu là FO2, DQ52, DQ41, DQ42, DD3, DD4, DQ52, DQ82, FO1, DQ81 sinh trưởng tốt nhất (∆OD800>1).
Song song với thí nghiệm xác định khả năng sinh trưởng của 32 chủng VKTQH chúng tôi tiến hành thí nghiệm đánh giá khả năng tạo màng sinh học.

Hình 3.3. Khả năng tạo màng sinh học dựa trên khả năng bắt giữ tím tinh thể của màng sinh học do các chủng VKTQH tạo thành

Hình 3.4. Khả năng tạo màng sinh học của các chủng VKTQH phân hủy hydrocarbon dầu mỏ và Acinetobacter calcoaceticus P23 (K: đối chứng âm)
Kết quả tạo màng sinh học của 32 chủng VKTQH được so sánh với chủng chủng P23 là đối chứng dương [124] cho thấy 10 chủng là FO2, DQ52, DQ41, DQ42, DD3, DD4, DQ52, DQ82, FO1, DQ81 tạo màng sinh học tốt hơn so với chủng P23 là đối chứng dương có giá trị OD600 đạt 17,6 (Hình 3.3 và 3.4). Trong đó, bốn chủng VKTQH, bao gồm DQ41, DQ51, DD4 và DQ82 có khả năng hình thành màng sinh học mạnh, giá trị OD600 từ 20,6 đến 22,4 và tiếp tục tăng sau 7 ngày nuôi cấy (Hình 3.3 và Hình 3.4). Do đó, chúng tôi lựa chọn 10 chủng này để thực hiện các nghiên cứu tiếp theo.
3.1.2.2. Khả năng sử dụng hydrocarbon dầu mỏ của các chủng vi khuẩn tía quang hợp
Thí nghiệm đánh giá khả năng sinh trưởng trên các nguồn hydrocarbon dầu mỏ của 10 chủng VKTQH có khả năng tạo màng sinh học tốt. Cụ thể, thí nghiệm
được thực hiện bằng cách thay thế acetate trong thành phần của môi trường DSMZ 27 bằng các cơ chất khác nhau, bao gồm dầu diesel, toluene, naphthalene, phenol và pyrene.
(i) Khả năng sinh trưởng của 10 chủng VKTQH trên dầu diesel
Kết quả cho thấy cả 10 chủng VKTQH đều ghi nhận có khả năng sinh trưởng tốt trong môi trường có bổ sung cơ chất dầu diesel nồng độ 4 – 8% (Hình 3.5, Hình 3.6), đáng chú ý nhất là 3 chủng DQ41, FO2 và DD4.

Hình 3.5. Khả năng sinh trưởng của 10 chủng VKTQH sau 7 ngày nuôi cấy ở các nồng độ dầu diesel khác nhau

Hình 3.6. Dịch nuôi cấy của 10 chủng VKTQH ở 10 % dầu diesel sau 7 ngày Cụ thể, dựa vào màu sắc dịch huyền phù và đo độ hấp phụ quang học dịch
huyền phù tế bào ở bước sóng 800 nm, các chủng VKTQH đã được lựa chọn đều có
khả năng sinh trưởng trên môi trường chứa dầu diesel với nồng độ từ 4 - 10% (v/v), tốt nhất trong khoảng 4 - 8% (v/v), chậm sinh trưởng ở nồng độ dầu 9 ÷ 10%.
(ii) Khả năng sinh trưởng của 10 chủng VKTQH trên toluene
Toluene là một thành viên trong nhóm chất BTEX (gồm benzene, toluene, ethylbenzene và xylene), là nhóm chất ô nhiễm phổ biến trong các khí thải công nghiệp, nước thải của các nhà máy keo, dung môi, thuốc nhuộm [57]. Khả năng sử dụng toluene cũng được xem là một trong những tiêu chí quan trọng khi nghiên cứu về đặc tính của 10 chủng VKTQH trong luận án này.
Dựa vào độ hấp phụ quang học dịch huyền phù tế bào nuôi trong môi trường có bổ sung toluene ở các nồng độ khác nhau trong 7 ngày đo ở bước sóng 800 nm (Hình 3.7) và màu sắc dịch huyền phù (Hình 3.8), chúng tôi nhận thấy ở nồng độ 150 ppm chủng FO2 và DQ52 phát triển mạnh nhất (∆OD800 > 1), ở nồng độ 200 ppm chủng DQ41, DD4, DQ52 và FO2 sinh trưởng mạnh (∆OD800 > 1), ở nồng độ 250 ppm chủng DQ41, FO2 và DD4 sinh trưởng mạnh (∆OD800 > 1), đến nồng độ 300 ppm OD sinh trưởng của cả 10 chủng đều bị giảm, đặc biệt là 3 chủng DQ52, DQ81 và DD82 (∆OD800 < 0,8). Ba chủng DQ41, FO2 và DD4 vẫn có thể sinh trưởng khá tốt (0.9 <∆OD800 <1,0).

Hình 3.7. Khả năng sinh trưởng của 10 chủng VKTQH ở các nồng độ toluene khác nhau sau 7 ngày nuôi cấy

Hình 3.8. Dịch nuôi cấy của 10 chủng VKTQH ở 250 ppm toluene sau 7 ngày
Trên thực tế, mức độ gây độc của toluene trong môi trường nước được chỉ ra là ≥ 50 ppm [136], như vậy nồng độ toluene 200 ppm là nồng độ cao, ức chế nhiều loài sinh vật. Do đó, 4 chủng DQ41, DD4, DQ52 và FO2 được chúng tôi lựa chọn là các chủng có khả năng sinh trưởng tốt trên toluene.
(iii) Khả năng sinh trưởng của 10 chủng VKTQH trên phenol
10 chủng VKTQH đã được nuôi cấy trong môi trường DSMZ 27 có bổ sung phenol với các nồng độ 150, 200, 250 và 300 ppm làm nguồn carbon và năng lượng duy nhất. Sau 7 ngày nuôi cấy, khả năng sinh trưởng của các chủng được thể hiện ở Hình 3.9 và Hình 3.10.

Hình 3.9. Khả năng sinh trưởng của 10 chủng VKTQH sau 7 ngày nuôi cấy ở các nồng độ phenol khác nhau

Hình 3.10. Dịch nuôi cấy của 10 chủng VKTQH ở 150 ppm phenol sau 7 ngày Dựa vào độ hấp phụ quang học dịch huyền phù tế bào ở bước sóng 800 nm
màu sắc dịch huyền phù (Hình 3.9) và màu sắc dịch huyền phù (Hình 3.10) chúng
tôi nhận thấy, ở nồng độ 150 ppm, hầu hết các chủng VKTQH đều có khả năng sinh